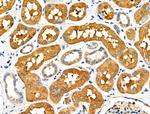
PCK1 Antibody in Immunohistochemistry (Paraffin) (IHC (P))

Search
Invitrogen
PCK1 Polyclonal Antibody
{{$productOrderCtrl.translations['antibody.pdp.commerceCard.promotion.promotions']}}
{{$productOrderCtrl.translations['antibody.pdp.commerceCard.promotion.viewpromo']}}
{{$productOrderCtrl.translations['antibody.pdp.commerceCard.promotion.promocode']}}: {{promo.promoCode}} {{promo.promoTitle}} {{promo.promoDescription}}. {{$productOrderCtrl.translations['antibody.pdp.commerceCard.promotion.learnmore']}}
图: 1 / 5
PCK1 Antibody (PA5-118872) in ICC/IF

Please note: We are reviewing Western blot images included in the antibody testing data in our catalog, including those provided by third parties. Unless expressly labeled or annotated as “raw-unedited”, Western blot images included in the antibody testing data in our catalog may have been edited, optimized or otherwise adjusted for presentation.
产品信息
PA5-118872
种属反应
宿主/亚型
分类
类型
抗原
偶联物
形式
浓度
规格
纯化类型
保存液
内含物
保存条件
运输条件
RRID
产品详细信息
Antibody detects endogenous levels of total PCK1.
靶标信息
Phosphoenolpyruvate Carboxykinase 1 (PCK1) is a main control point for the regulation of gluconeogenesis. During gluconeogenesis PCK1 acts as the rate-limiting enzyme. PCK1 regulates the formation and maintenance of memory CH8(+) T-cells via gluconeogenesis. PCK1 aids in controlling the levels of metabolic intermediates in the citric acid cycle by regulating cataplerosis and anaplerosis. When glucose levels are high, PCK1 catalyzes the cataplerotic conversion of oxaloacetate to phosphoenolpyruvate (PEP). When they are low it catalyzes the anaplerotic conversion of phosphoenolpyruvate to oxaloacetate. When phosphorylated at Ser-90 by AKT1, PCK1 acts as a protein kinase by reducing the binding affinity to oxaloacetate and promotes an atypical serine protein kinase activity using GTP as the donor. This activity regulates lipogenesis by disrupting the interaction between INSIG proteins and SCAP and promoting nuclear translocation of SREBP proteins and transcription of lipogenesis-related genes. An important paralog of this gene is PCK2.
仅用于科研。不用于诊断过程。未经明确授权不得转售。
篇参考文献 (0)
生物信息学
蛋白别名: HGNC:8724; MGC22652; PE PEPCKC; PEPCK-C; phosphoenolpyruvate carboxykinase (GTP); phosphoenolpyruvate carboxykinase 1, cytosolic; phosphoenolpyruvate carboxykinase, cytosolic; phosphoenolpyruvate carboxykinase, cytosolic (GTP); Phosphoenolpyruvate carboxykinase, cytosolic [GTP]; phosphoenolpyruvate carboxylase; Serine-protein kinase PCK1
基因别名: AI265463; GTP; PCK; Pck-1; PCK1; PEPCK; PEPCK-C; PEPCK1; RATPEPCK
UniProt ID: (Rat) P07379, (Mouse) Q9Z2V4
Entrez Gene ID: (Rat) 362282, (Mouse) 18534




